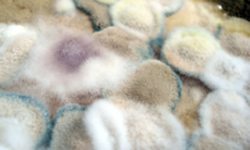

Toda la actualidad de
Secrets of the Screen
The British Museum. Secrets of the Screen. [DVD]. Abe, Mitsuhiro; [...]
La técnica japonesa para elaborar engrudo
Blasi, Berta La tècnica japonesa para elaborar engrudo [en línea]. [...]
Plan de evacuación del patrimonio documental en bibliotecas
Prieto Gutiérrez, Juan José Plan de evacuación del patrimonio documental [...]
Hongos ambientales en una biblioteca: un año de estudio
Bueno, Dante J. and Silva, Julio O. and Oliver, Guillermo [...]
Art Conservation
Art Conservation es una empresa multidisciplinar con sede en Holanda [...]